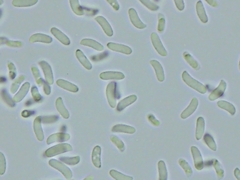
Radulomyces rickii
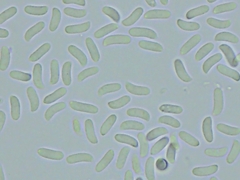
Radulomyces rickii

Radulomyces rickii: taxon details and analytics
- Domain
- Kingdom
- Fungi
- Phylum
- Basidiomycota
- Class
- Agaricomycetes
- Order
- Agaricales
- Family
- Radulomycetaceae
- Genus
- Radulomyces
- Species
- Radulomyces rickii
- Scientific Name
- Radulomyces rickii
Summary description from Wikipedia:
Radulomyces rickii
Radulomyces rickii är en svampart som först beskrevs av Giacopo Bresàdola, och fick sitt nu gällande namn av Mads Peter Christiansen 1960. Radulomyces rickii ingår i släktet Radulomyces och familjen mattsvampar. Inga underarter finns listade i Catalogue of Life.
...Radulomyces rickii in languages:
- Dutch
- Bolsporige boomkorst
Images from inaturalist.org observations:
We recommend you sign up for this excellent, free service.